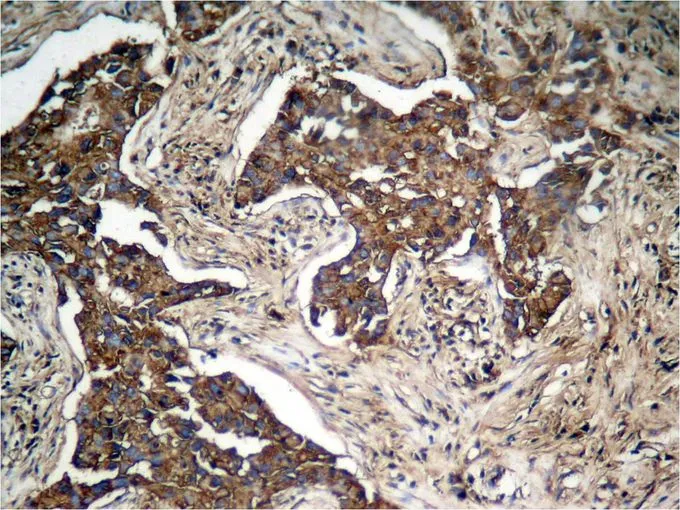

ICC/IF analysis of methanol-fixed MCF-7 cells using GTX50146 Her2 / ErbB2 (phospho Tyr1248) antibody.
Her2 / ErbB2 (phospho Tyr1248) antibody
GTX50146
ApplicationsImmunoFluorescence, Western Blot, ImmunoCytoChemistry, ImmunoHistoChemistry, ImmunoHistoChemistry Paraffin
Product group Antibodies
ReactivityHuman
TargetERBB2
Overview
- SupplierGeneTex
- Product NameHer2 / ErbB2 (phospho Tyr1248) antibody
- Delivery Days Customer9
- Application Supplier NoteWB: 1:500-1:1000. ICC/IF: 1:100-1:200. IHC-P: 1:50-1:100. *Optimal dilutions/concentrations should be determined by the researcher.Not tested in other applications.
- ApplicationsImmunoFluorescence, Western Blot, ImmunoCytoChemistry, ImmunoHistoChemistry, ImmunoHistoChemistry Paraffin
- CertificationResearch Use Only
- ClonalityPolyclonal
- Concentration1 mg/ml
- ConjugateUnconjugated
- Gene ID2064
- Target nameERBB2
- Target descriptionerb-b2 receptor tyrosine kinase 2
- Target synonymsCD340, HER-2, HER-2/neu, HER2, MLN 19, MLN-19, NEU, NGL, TKR1, VSCN2, c-ERB-2, c-ERB2, p185(erbB2), receptor tyrosine-protein kinase erbB-2, c-erb B2/neu protein, herstatin, human epidermal growth factor receptor 2, metastatic lymph node gene 19 protein, neuro/glioblastoma derived oncogene homolog, neuroblastoma/glioblastoma derived oncogene homolog, proto-oncogene Neu, proto-oncogene c-ErbB-2, tyrosine kinase-type cell surface receptor HER2, v-erb-b2 avian erythroblastic leukemia viral oncogene homolog 2, v-erb-b2 avian erythroblastic leukemia viral oncoprotein 2, v-erb-b2 erythroblastic leukemia viral oncogene homolog 2, neuro/glioblastoma derived oncogene homolog
- HostRabbit
- IsotypeIgG
- Protein IDP04626
- Protein NameReceptor tyrosine-protein kinase erbB-2
- Scientific DescriptionThis gene encodes a member of the epidermal growth factor (EGF) receptor family of receptor tyrosine kinases. This protein has no ligand binding domain of its own and therefore cannot bind growth factors. However, it does bind tightly to other ligand-bound EGF receptor family members to form a heterodimer, stabilizing ligand binding and enhancing kinase-mediated activation of downstream signalling pathways, such as those involving mitogen-activated protein kinase and phosphatidylinositol-3 kinase. Allelic variations at amino acid positions 654 and 655 of isoform a (positions 624 and 625 of isoform b) have been reported, with the most common allele, Ile654/Ile655, shown here. Amplification and/or overexpression of this gene has been reported in numerous cancers, including breast and ovarian tumors. Alternative splicing results in several additional transcript variants, some encoding different isoforms and others that have not been fully characterized. [provided by RefSeq, Jul 2008]
- ReactivityHuman
- Storage Instruction-20°C or -80°C,2°C to 8°C
- UNSPSC12352203

![FACS analysis of MCF-7 cells using GTX82764 Her2 / ErbB2 antibody [6C2]. Green : Her2 / ErbB2 Purple : negative control](https://www.genetex.com/upload/website/prouct_img/normal/GTX82764/GTX82764_20170912_FACS_w_23061322_297.webp)